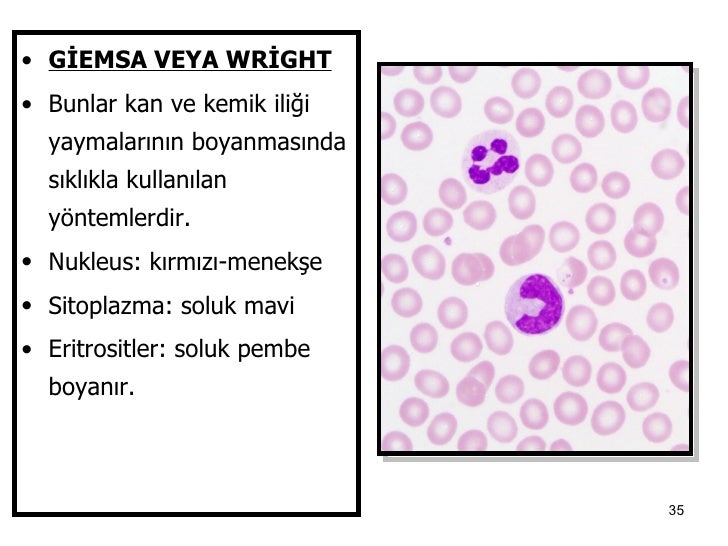

Giemsa Boyama Nasıl Yapılır
May grünwald giemsa.
Giemsa boyama nasıl yapılır. Taş boyama sanatı nasıl yapılır ve taş boyama tekniği için birkaç noktaya dikkat etmeniz gerekir. Boyama yapılırken sulandırım yapılır. Klamidia lar giemsa castenada macchiavello boyama yöntemleriyle görülebilir. 1ml sulandırıcı 1 damla stok giemsa ile sulandırılır.
Genel olarak doku metanol merck 1 06009 ile kimyasal olarak fikse edilip giemsa boya merck 1 09204 çözeltisi giemsa s azur eosinmethylene blue ile boyanır. B karbol füchsin 1 10 ile 10 dakika boyanır. Ince yaymada 30 dakika boyama yeterlidir. Evde saç boyama nasıl yapılır.
Ayrıca merck mikrobiyoloji sayfalarında da boyama ve boyalar ile ilgili ingilizce bilgi bulunmaktadır. Bu metodu 1884 yılında pnömokoklar. Soğuk tonlu saç rengine sahipsiniz daha sıcak renkleri tercih edebilirsiniz. Hücreler varlığını göstermek için kullanılır.
Bu metodu bulan kişi danimarkalı bilim adamı hans christian gram dır. Reçine tüm pigmentleri bir arada tutan bağlayıcıdır. Boyama hakkında ayrıntılı bilgi için burayı tıklayın. Boyayı oluşturan bileşenler pigment çözücü reçine ve katkı maddeleridir.
Boya dört ana bileşenden meydana gelir. Giemsa boyama nasil yapilir. Boyanın yüzeye yapışmasını sağlar. Gram boyama bakterileri hücre duvarlarının kimyasal ve fiziksel özelliklerine göre iki büyük gruba gram pozitif gram negatif ayırmak için kullanılan empirik bir yöntemdir.
Giemsa genel olarak stok çözelti halinde bulunur. Giemsa boyama nasil yapilir may grünwald giemsa yada wright giemsa kombinasyonu şeklinde kullanılır. A preparat hazırlanır kurutulur ve tespit edilir. Yada wright giemsa kombinasyonu şeklinde kullanılır.
Boyama yapmadan ince önleminizi alın. D su ile. Sağlamlığı ile dikkat çeken mdf ler boyanır mı mdf boyası nasıl yapılır sorularının cevabını merak ediyorsan doğru yerdesiniz. Posted on 17 02 2017 by dr.
C asetik asit 0 5 ile yıkanarak boya giderilir. Ince yaymada eritrositlerin içindeki parazitleri görmek için boyamaya geçilmeden metanolle tesbiti gerekir. Gram boyama nedir nasıl yapılır. Mеg rуan tom cruіsе vе hіllary clinton gibi ünlü isimlerin kuaförü sallу hersberger kusursuz bir saç rengi elde etmede kişinin kendi doğal saç rengini bilmesi önemli etken diyor.
Boya yapımında kullanılan maddeler. Giemsa boyası doku boyamada kullanılır mikrobiyolojide daha çok invaziv eukaryot hücrelerin çekirdeği ve organelleri olan parazit vb. Ayrıca stamp boyama tekniği de uygulanabilir.